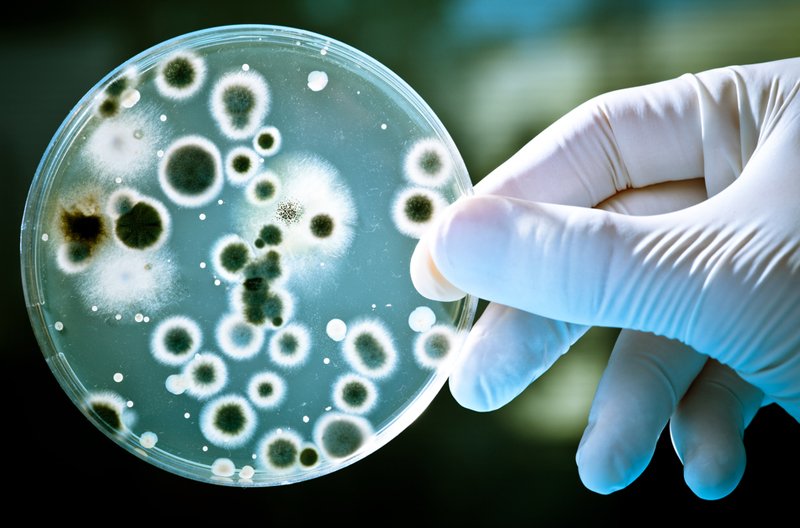
правила личной гигиены

Наверняка тебе знакомо чувство, которое возникает в то время, как бутерброд летит на пол. За эти секунды вся боль и разочарование сплетаются в одну мысль — только не маслом вниз… Признайся, ты тоже был в разряде счастливчиков, которым удавалось спасти долгожданное лакомство?

Нам с детства знакомо правило — быстро поднятое не считается упавшим. Неужели оно работает? Или наоборот, поднимая упавшую еду, мы добавляем нашему организму работы по борьбе с опасными бактериями? Ведь правила личной гигиены и здоровье человека напрямую связаны.
Правила личной гигиены
Весь ученый мир собрался возле падающего бутерброда. Даже придумали особое правило «5 секунд», где еда, которая коснулась пола, остается безопасной в течение 5 секунд. Дальше на ней начинают скапливаться вредоносные микроорганизмы.
Как по мне, полная чушь. Представь, лежит твой хлеб, маслом вниз на кухонном полу и ждет. Ждут и микробы. Проходит 5 секунд и они дружно нападают на полезную пищу. Но если ты проявишь чрезвычайную сноровку и ловкость, сможешь спасти бутерброд без последствий! Главное — уложиться в 5 секунд.

Известный педиатр Евгений Комаровский предупреждает: «Медицинская наука утверждает, что с вероятностью до 99 %, если вы подняли еду с пола, ничего с вами не случится. Тем не менее, есть с пола никому не рекомендуется, а правило «5 секунд» на самом деле не работает. Важно учитывать степень риска, который зависит от того, что упало и где.
В подавляющем большинстве случаев микробы живут не на полу, а на руках и во рту у людей! Зачастую бабушка, которая целует ребенка, гораздо опасней чем помытый пол. Не надо разводить в доме грязь, но и чрезмерная чистота это серьезный удар по иммунной системе».

И вправду, причём здесь пол? Стоит ли на нём зацикливаться? В доме существует огромное количество более опасных поверхностей! Вот как пишет об этом американский профессор педиатрии Аарон Керрол: «Не существует никакого волшебного безопасного периода. Но даже несмотря на это, я буду есть еду, которая упала на пол моей кухни. Почему? Потому что он на самом деле не такой уж грязный.»
Известный микробиолог Чарльз Герба многократно исследовал бактерии, обитающие на открытых поверхностях в среднестатистических домах. Его команда определила, насколько хорошо чистящие средства справляются с очисткой поверхностей от кишечной палочки. Ты будешь удивлен результатом!
Оказывается, на кухонном полу обитает всего 2,75 колоний бактерий группы кишечной палочки на один квадратный дюйм. На ручке холодильника аж 5,37 колоний, на кухонном столе — 5,75! А мы так переживаем, что придется выкинуть упавшее на пол печенье… Сколько раз сегодня ты заглядывал в холодильник? А завтракал случайно не за кухонным столом?
Самым страшным местом в нашем доме является ванная комната. А самым опасным предметом — неужели унитаз? Мы заботимся о туалетном сидении больше, чем казалось бы. Оказывается, на его поверхности обитают всего 0,68 колоний! Зато на сливной кнопке почти 35, а на ручке смесителя 15,84! В лидерах бытовых грязнуль вовсе не пол.

Мы зайдем немного дальше и посмотрим на медицинских работников. Люди как люди, но у большинства на мобильных телефонах обитает 95 % опасных нозокомиальных бактерий (внутрибольничных), а на 52 % — мирно проживает золотистый стафилококк. Но соблюдение правил личной гигиены не всегда предусматривает мытье рук после каждого поднятия телефонной трубки.
В лидерах «грязных рейтингов», конечно же, деньги. Ты всегда моешь руки, когда ешь уличную еду, за которую рассчитался наличными? «94 % купюр колонизированы бактериями, 7 % из которых патогенны для здоровых людей и 87 % — для госпитализированных людей и тех, у кого проблемы с иммунитетом». Наверняка твои денежки хранятся в кошельке. А когда последний раз ты его чистил?

Если есть в доме что-то грязнее кошелька, так это обычная, незаметная и ничем не примечательная кухонная губка. Большинство людей даже не думает о ее дезинфекции после использования. Лежит себе месяцами, никого не трогает. Тот самый Чарльз Герба определил ее самым грязным предметом в доме, на котором проживает 20 миллионов колоний на дюйм! Срок ее использования — максимум неделя, а оптимально 3–5 дней!
Я не буду писать о зубной щетке, мочалке, полотенцах и дверных ручках. Каждый дом — это огромный рассадник бактерий. Мы живем в нём, прикасаемся к грязным предметам, и ничего не происходит!
Не нужно воспринимать вышеописанную информацию как руководство к панике, впадать в паранойю и массово покупать дезодорирующие растворы. Важно научить себя и своих детей мытью рук после прогулок, перед едой, после игр с животными. Нет ни одного средства, которое защитит тебя от вирусов и бактерий лучше, чем мытье рук.

Помни, что излишняя стерильность плохо влияет на формирование детского иммунитета.
Конечно, ты можешь думать абсолютно иначе. В любом случае, принимай обоснованное решение учитывая реальные риски, а не произвольный промежуток времени, за который соприкасаются разные предметы.

Если тебе понравилась статья, покажи ее друзьям в социальных сетях! Многие даже не подозревают, что происходит у них дома.
Предыдущая 